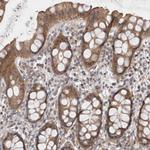
GSDMB Antibody in Immunohistochemistry (Paraffin) (IHC (P))

Search
Invitrogen
GSDMB Polyclonal Antibody
{{$productOrderCtrl.translations['antibody.pdp.commerceCard.promotion.promotions']}}
{{$productOrderCtrl.translations['antibody.pdp.commerceCard.promotion.viewpromo']}}
{{$productOrderCtrl.translations['antibody.pdp.commerceCard.promotion.promocode']}}: {{promo.promoCode}} {{promo.promoTitle}} {{promo.promoDescription}}. {{$productOrderCtrl.translations['antibody.pdp.commerceCard.promotion.learnmore']}}
产品信息
PA5-54929
种属反应
宿主/亚型
分类
类型
抗原
偶联物
形式
浓度
规格
纯化类型
保存液
内含物
保存条件
运输条件
RRID
产品详细信息
Immunogen sequence: AGGDMIAVRS LVDADRFRCF HLVGEKRTFF GCRHYTTGLT LMDILDTDGD KWLDELDSGL QGQKAEFQIL DNVDSTGELI VRLPKEIT
Highest antigen sequence identity to the following orthologs: Mouse - 34%, Rat - 33%.
靶标信息
This gene encodes a member of the gasdermin-domain containing protein family. Other gasdermin-family genes are implicated in the regulation of apoptosis in epithelial cells, and are linked to cancer. Multiple transcript variants encoding different isoforms have been found for this gene. Additional variants have been described, but they are candidates for nonsense-mediated mRNA decay (NMD) and are unlikely to be protein-coding.
仅用于科研。不用于诊断过程。未经明确授权不得转售。
篇参考文献 (0)
生物信息学
蛋白别名: Gasdermin-B; Gasdermin-like protein; gasderminB-1; unnamed protein product
基因别名: GSDMB; GSDMB-1; GSDML; PP4052; PRO2521
UniProt ID: (Human) Q8TAX9
Entrez Gene ID: (Human) 55876